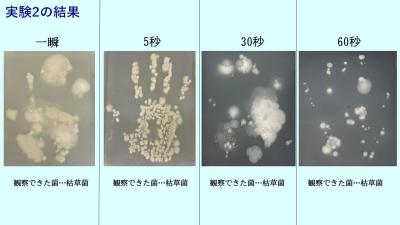
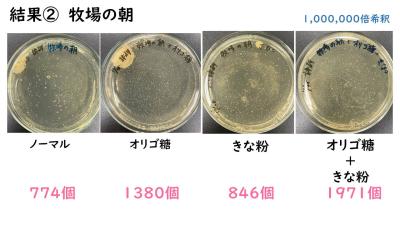

Home | 連絡先・所在地・アクセス | リンク
2023年1月の記事一覧
★物質工学科3年「課題研究」フォトギャラリー★
1/30(月)に行われた物質工学科3年生の課題研究の様子をフォトギャラリー形式で紹介します。
本日もたくさんの保護者の皆様に来校していただき、感謝申し上げます。
今年度末で物質工学科は閉科しますので、今回が最後の課題研究発表会となりました。
土木施工の技術講演会が行われました
1月30日(月)、都市基盤工学科2年生と理工科1年生を対象として、一般社団法人 静岡県土木施工管理技士会の方々に講師を務めていただき「土木施工の技術講演会」を行いました。
この講演会は、土木の仕事を知り、将来の進路を考えることを目的としています。
「海岸工事について」、「高架橋の下部工が出来るまで」、「深礎杭SB20工事」、「ICT技術を活用した点群測量とCIMについて」の4つの発表を聞き、その後質疑応答を行いました。
多くの生徒から活発な質問があり、それぞれ丁寧に応えていただきました。
ロボットアイディア甲子園 全国大会(大阪工業大学)
1月28日(土)大阪工業大学で『ロボットアイディア甲子園』が開催され、ロボット工学科2年杉山駿太君が出場しました。
産業用ロボットを活用していくアイディアをプレゼンテーションで競う試合です。沖縄から宮城県までの各ブロックの代表者25名で争いました。杉山君は県大会で優勝して本大会に臨みました。午前中のポスタープレゼンテーションの10名の予選が通りませんでしたが、着眼点・アイディアが評価され、ユニーク賞を得ることが出来ました。
★都市基盤工学科3年生がNEXCO中日本様による現場見学会に参加しました★
1月26日(木)本校都市基盤工学科3年生が、NEXCO中日本様による現場見学会に参加しました。静岡保全・サービスセンターにて、高速道路の役割や次世代技術を活用した革新的な高速道路保全マネジメントi-MOVEMENTなどについて学びました。
菅ケ谷リニューアル工事を見学後、東名高速道路焼津インターチェンジ函渠工事の様子を見学させていただきました。
3年生も家庭学習期間まであと1週間になりました。まずは1/31から始まる最後の定期テストに向けて頑張って勉強をして欲しいです。
電気工学科 キャリア教育について
電気工学科1、2年生を対象とした、キャリア教育を
下記内容にて開催しました。
1月26日(木) 2年生対象 10:35~12:25
・資格と職業について 名古屋工学院専門学校 石原先生
・NTTファシリティーズの大規模災害における取組について
株式会社NTTファシリティーズ 今井先生
1月27日(金) 1年生対象 10:25~11:10
・資格と職業について 名古屋工学院専門学校 石原先生
・トヨタ自動車の電気保安について
トヨタ自動車株式会社 大前先生
資格と職業についての講話では、電気の仕事は、資格がないと行うことができない特殊性があること。そして、資格を持つことが、より良いキャリア形成につながること。電気業界は人材不足で、電気を学ぶ生徒は、社会から求められ必要とされていること。高度な資格を取得することは、安定した雇用につながるということを教えていただきました。
㈱NTTファシリティーズ様の講話では、東北大震災において、通信設備が壊滅的な損害を被ってしまったが、東北の人々の安心のために、通信(スマホ、携帯電話など)を迅速に復旧することを使命に、陣頭に指揮に立ち、設備の復旧、再建を行ったお話を伺いました。また、通信設備の復旧には、電気が欠かせないものであることも、あらためて教えていただきました。

電気工学科 1,2年生ともに、真剣に聴いてる生徒たちの様子です。
電気業界は人材不足であり、講義を聴いている、生徒たちの活躍が、社会から求められています。今後、資格を取り、大きく羽ばたいていくことでしょう!
★第11回静岡県ものづくり競技大会旋盤部門・公開練習が行われました★
令和5年1月28日(土)に本校をメイン会場として、「第11回静岡県ものづくり競技大会」(若年者ものづくり競技大会静岡県予選・高校生ものづくりコンテスト静岡県大会)が本校で行われます。
先立ちまして、1月27日(金)午後に、「旋盤部門」の公開練習を行いました。
本校からは、高校生の部・旋盤部門に機械工学科2年生・平井康君と1年生・鈴木君の2名が参加します。
この「ものづくり大会」は、工業高校・専門学校等で技能の習得に取り組む生徒等を対象とした競技大会で、静岡県のものづくり産業を支える若い技能者の技能向上を図る目的であるとともに、次の東海大会への出場権を賭けた大会でもあります。
「旋盤部門」の公開練習の一コマを掲載させていただきます。真剣なまなざしにご注目ください。大会本番での活躍を心から祈っています。
★電子工学科・機械工学科・情報システム科・課題研究フォトギャラリー★
1/26(木)に行われた電子工学科3年と機械工学科3年・情報システム科3年の課題研究の様子をフォトギャラリー形式で紹介します。
正式な記事は後日、総務課・web担当が掲載しますので、あくまで様子をお知らせする形でご覧ください。本日もたくさんの保護者の皆様に来校していただき、感謝申し上げます。
工業科最後は1/30(月)に物質工学科3年生が課題研究発表会を行います。
まずは電子工学科です。今年度末で電子工学科は閉科しますので、今回が最後の課題研究発表会となりました。
各班のマイコンカー制作発表です。
たくさん保護者の皆様も聴講に来てくださいました。
生徒たちが制作したマイコンカーです。
マイコンカーラリーの全国大会に出場した佐藤君の報告会も行われました。
最後に各班のマイコンカーの試走を見せてくれました。
続いて機械工学科です。
「溶接アートに挑戦」の班、溶接アートコンクールに出品した作品の報告がありました。こちらはバイク・HONDA CB1100を制作した班。
こちらは「水力発電機の発電効率の向上」を研究した班と、「SL模型製作」を行った班の作品展示です。
こちらは「スピーカーの製作」を行った班です。
こちらは「ガウス加速器」の研究を行った班の発表です。
最後に情報システム科。
文字を打つ「タイピング技術」を用いて「タイピングゲームの制作」を行った班の発表です。
2年生も次年度の題材の参考にするために聴講しました。時折質疑も飛び出し、熱を帯びていました。
「赤外線を使用した射的ゲームの制作」を行った班。実際に今年度の文化祭でお客様相手に行った射的ゲームの成果と反省を発表してくれました。
★学校保健委員会を開催しました★
1月25日(水)午後、本校で「令和4年度 学校保健委員会」を開催しました。
学校保健委員会は、新型コロナウイルス感染症の関係で3年間開催できず書面開催を続けてきましたが、今回感染症対策の一環でZOOM形式となりましたが、3年ぶりに開催することが出来ました。
学校医・学校歯科医・学校薬剤師の先生方、ならびにPTA学校保健委員の方々もZOOMにて参加していただきました。

学校側からは、本校の学校保健安全計画、定期健康診断結果、保健室利用状況、治療状況、朝食調査の結果、災害発生状況、相談室の利用状況、新体力テストの分析などの報告および来年度の学校保健安全計画の提案および説明を行いました。
また、委員会冒頭では生徒保健委員会の研究発表が行なわれ、2年生の角田君(ロボット工学科)、竹中君(電子物質工学科)が、「歯と口の健康を守ろう」という題目でパワーポイントを駆使し、素晴らしい発表をしてくれました。
発表終了後、学校医から御助言を頂きました。
★都市基盤工学科3年・電気工学科3年「課題研究」フォトギャラリー★
1/24(火)に行われた都市基盤工学科3年と電気工学科3年の課題研究の様子をフォトギャラリー形式で紹介します。
正式な記事は後日、総務課・web担当が掲載しますので、あくまで様子をお知らせする形でご覧ください。本日もたくさんの保護者の皆様に来校していただき、感謝申し上げます。
都市基盤工学科です。
裾野市で(株)トヨタ自動車が企画する「ウーブンシティー」についての研究
まちづくり~魅力あるまちづくりをするために~
フォトロゲイニングを活用して、静岡県の魅力を探る研究
土木と農業の研究
電気工学科の課題研究
太陽光発電を用いた紙コップディスペンサー
きちんと紙コップが落ちてきた瞬間は感動的でした。
風レンズと羽根のない風力発電の研究
その他の制作作品です。
太陽光パネルを利用した食料庫の研究
ブッシングピンポンの作成
PLCを利用したエレベーター装置の制作
コイルガンの研究
ベルトン水車の作成
次回は1/26(木)午後、機械工学科・情報システム科・電子工学科が行います。
ロボット工学科3年生による課題研究発表会が行われました
1月19日(木)の午後、視聴覚室にてロボット工学科3年生による課題研究発表会が行われました。
以下に研究内容を掲載します。
1班 「小型自動販売機の製作」
PLC制御を用いた自動販売機の製作。硬貨を入れるとランプが点灯し、欲しい飲み物のボタンを押すと往復スライダ・クランク機構により商品が押し出される。
2班 「自動アルコールディスペンサーの製作」
赤外線センサに手をかざすとサーボモータが既定の角度まで回転し、ボトルのポンプが押されることで少量のアルコールが噴射される。その後、自動でサーボモータが元の位置まで回転しボトルのポンプを引き上げることで一連の動作が完了となる。
3班 「オーバーフロー水槽の製作」
オーバーフローシステムを塩ビ管と水中ポンプで再現した。また濾過槽は三層にわけ濾過能力をさらに高めた。ペルチェ素子を用いた水温制御も行った。
4班 「潜水艦の研究」
水中で動作させるためにブラシレスモータを採用し、プラスチック製の注射器を用いて艦内に水を取り入れ、浮力を調整する。スクリューは 3DCAD を用いて作成した。
5班 「自立歩行ロボット」
ステッピングモータを使用し、制御にはPICを使用した。PICからの微弱な電気信号をモータドライバーが受け取り、増幅しステッピングモータに流し、モータを制御している。リンク機構を用いて、ジョイントでの回転運動を直線運動に変換することで前進、モータが逆転すると後進する。
6班 「BB-8の製作」
micro:bitによる無線通信による操作が可能。下の球体の中の4輪の車による重心の変化によって転がる。上の頭は、下の車に設置された磁石に反応しながら常に真上に位置するため転がっても落下しない。
7班 「六足歩行ロボットの製作」
サソリを模倣した六足ロボット。Bluetooth通信によりスマートフォンでの操作が可能。アルミの薄板を折り紙の要領で加工し、サソリをイメージした外装にした。メンテナンスがしやすいように開けられる構造にした。
8班 「植物工場の製作」
土壌湿度センサにより土壌の湿度を測定し、ホースで繋がれたタンクから電動ポンプで湿度に応じた量をくみ上げ、散水することで土壌湿度を一定に保つことが出来る。光合成制御システムとして植物育成に有用な、赤色と青色の2色のLEDを設置した。
9班 「クレーンゲームの製作」
ボタン操作によりアームを景品の上に移動させ、下降上昇後、原点位置に戻るようにプログラムした。景品とアームの先端に磁石がつけてあるため、近づくと磁力により持ちあげることが出来る。
10班 「エアーホッケーの製作」
木材と塩化ビニル板で製作した密閉された本体に、エアブローを用いて空気を送る。本体の中で圧縮された空気が1025個の穴から放出されることでパックが浮き、摩擦を無視してゲームを行うことが出来る。ゴール内に赤外線センサを取り付け、パックが入ると得点板に反映される。
11班 「自作タイムブロッキングコンテナの製作」
スタートボタンを押したら一定時間蓋が開かず、中の物を取り出すことが出来ない。指定した時間が経過すると、接続しているソレノイドに電流が流れることによって蓋の固定を外し、ばね蝶番のバネで蓋が自動的に開く。
12班 「四足歩行ロボットの製作」
サーボモータという角度を調節することが出来るモータを8個使用し、独特な動きによって歩行する。外径は3Dプリンタによって製作し、赤外線を使ってリモコンからロボットに信号を送り、動かすことが出来る。